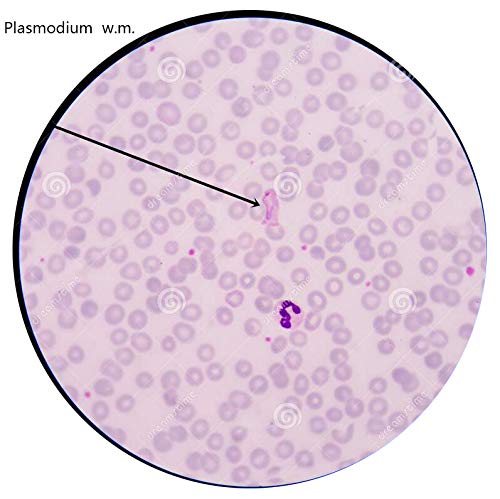
2 Prepared+Microscope+Education+Specimens+DIY+SCIENCE

- 【Protozoa Specimen Materials】- Representative animals of all species (4 class) of the protozoa phylum, Euglena - Amoeba Proteus - Plasmodium - Paramecium Caudatum - Trichodina
- 【Pre-Cleaned】 - Microscope slides are clean and free of any germs
- 【Easy to See Specimens】- Optical glass material, fresh sample, clear dyeing, suitable for most microscopes
- 【Kids Friendly Prepared Slides】 - Round corner, prevent cuts, safe for young students’ biology class
- 【Anti-Fall Packaging】 - Well-labled and protected against dampness moisture, shock and breakage
-
Information
-
Twitter
-
Pinterest
-
Youtube
-
Facebook

Ajit Ojha
Slides need to be kept in box and young children should have supervision.
Slides were appropriate for children in early grades. Slides also presented a variety of subject matter.